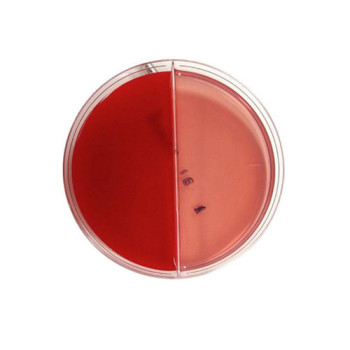

ΜΙΚΡΟΒΙΟΛΟΓΙΚΑ
Κωδικός προϊόντος: ALL-CCR402
..
0,00€
Χωρίς ΦΠΑ:0,00€
Κωδικός προϊόντος: SNS-318348
..
0,00€
Χωρίς ΦΠΑ:0,00€
Κωδικός προϊόντος: MRK-1092040500ME
Giemsa S Azur Eosin methylene Blue διάλυμα για μικροσκόπηση..
25,30€
Χωρίς ΦΠΑ:25,30€
Κωδικός προϊόντος: SNS-310517
..
0,00€
Χωρίς ΦΠΑ:0,00€
Κωδικός προϊόντος: ALL-IHC402
..
0,00€
Χωρίς ΦΠΑ:0,00€
Κωδικός προϊόντος: ALL-IHI402
..
0,00€
Χωρίς ΦΠΑ:0,00€
Κωδικός προϊόντος: SNS-351316
..
0,00€
Χωρίς ΦΠΑ:0,00€
Κωδικός προϊόντος: FL-28053
..
0,00€
Χωρίς ΦΠΑ:0,00€
Κωδικός προϊόντος: 010012
χψνβμνμ/,,΄¨,΄μνβμνωνβψνωχβφζσψνμβ..
6,70€
Χωρίς ΦΠΑ:6,70€
Κωδικός προϊόντος: ABD-EM0205
Σύστημα Ταυτοποίησης Τιτλοποίησης Αντιβιογράμματος για το ουρογενιτικό μυκόπλασμα...
70,00€
Χωρίς ΦΠΑ:70,00€
Κωδικός προϊόντος: FL-28094
..
0,00€
Χωρίς ΦΠΑ:0,00€
Κωδικός προϊόντος: FL-21050B
..
0,00€
Χωρίς ΦΠΑ:0,00€